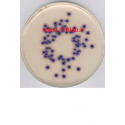
کلی فرم اگار Coliform Agar MERCK 110426

لاکتوز براس Lactose broth MERCK 107661
38,000,000 ریال
(بدون مالیات)

بلاد اگار Blood agar MERCK 110886
0 ریال
(بدون مالیات)

ام ار اس براس MRS broth MERCK 110661
0 ریال
(بدون مالیات)